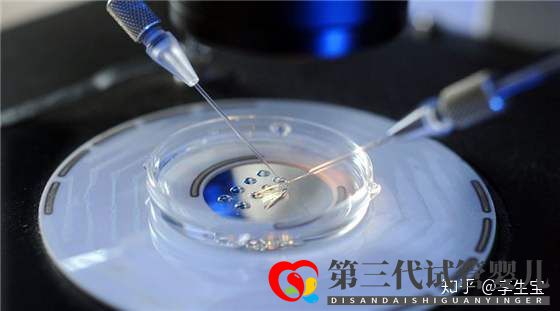
高龄做试管怎样才能提高成功率(图4) 高龄做试管怎样才能提高成功率(图4)

现在女性晚婚晚育的越来越多,一不小心很多人就错过了最佳生育时期,成为高龄备孕人群,甚至很多女性备孕一直没有成功,最后不得不借助试管婴儿辅助技术。但是做试管能做到一次成功吗?怎样提高试管成功率?


身体检查 随着年龄的增长,精子和卵子的质量也随之下降。女性如果准备生育,应该注意子宫。子宫情况差会影响到胚胎着床,从而导致试管失败。备孕夫妻双方应做孕前的全面身体检查,对于高龄妇女就更应进行孕前体检。高龄备孕前的体质调理试管前注意体质的调理,并且积极治疗本身就有的慢性病或其他疾病,才能在怀孕时给予宝宝最有利的生长环境,生活习惯要规律。在准备试管的半年前就戒烟、戒酒,充足的睡眠与平和心态易,增加受孕率。最重要的是科学饮食。备孕期间可吃些高蛋白、高纤维的食物。最好多吃些黑豆、豆浆、鱼汤等。研究发现:黑豆可以预防卵巢早衰,豆浆则可有效调整内分泌,避免内分泌失调而影响排卵;鱼汤可以促卵泡发育,利于女性排出优势卵泡。

高龄备孕前的卵巢调养 一般女性超过35岁之后,卵巢功能下降,在备孕期间或计划试管前期服用辅酶Q10等药物来对卵巢进行保养,辅酶Q10能激活人体细胞和细胞能量的营养,具有提高人体免疫力、延缓衰老等功能,在试管婴儿领域中,主要用于调养卵巢功能与提高卵子质量。 也可以补铁,为卵子提供营养。比如菠菜、动物内脏等富含铁元素较高的食品,为卵子的成熟做好准备工作。适当运动,增强免疫力 适当的体育锻炼能提高身体素质还能降低卵子发生染色体异常的可能,保证卵子质量。 适当的运动有助于促进血液循环,高龄女性做试管婴儿要参加适当的运动,提高自身的免疫力。心理调节,放松心情准备做试管的姐妹们。特别是女性朋友对月经,对排卵,对内膜,对输卵管给予高度重视,过度焦虑,如果压力过大,血管长期处在收缩状态,影响了子宫、卵巢局部的血流,造成子宫、输卵管肌肉收缩紊乱,胚胎不能着床而导致孕育失败。所以建议保持良好的心态和情绪,提高试管的成功率。高龄人群生育不容易,要经历比一般人更多的辛苦,但是只要坚持不懈,科学合理地调养身体,一定能拥有好孕。






